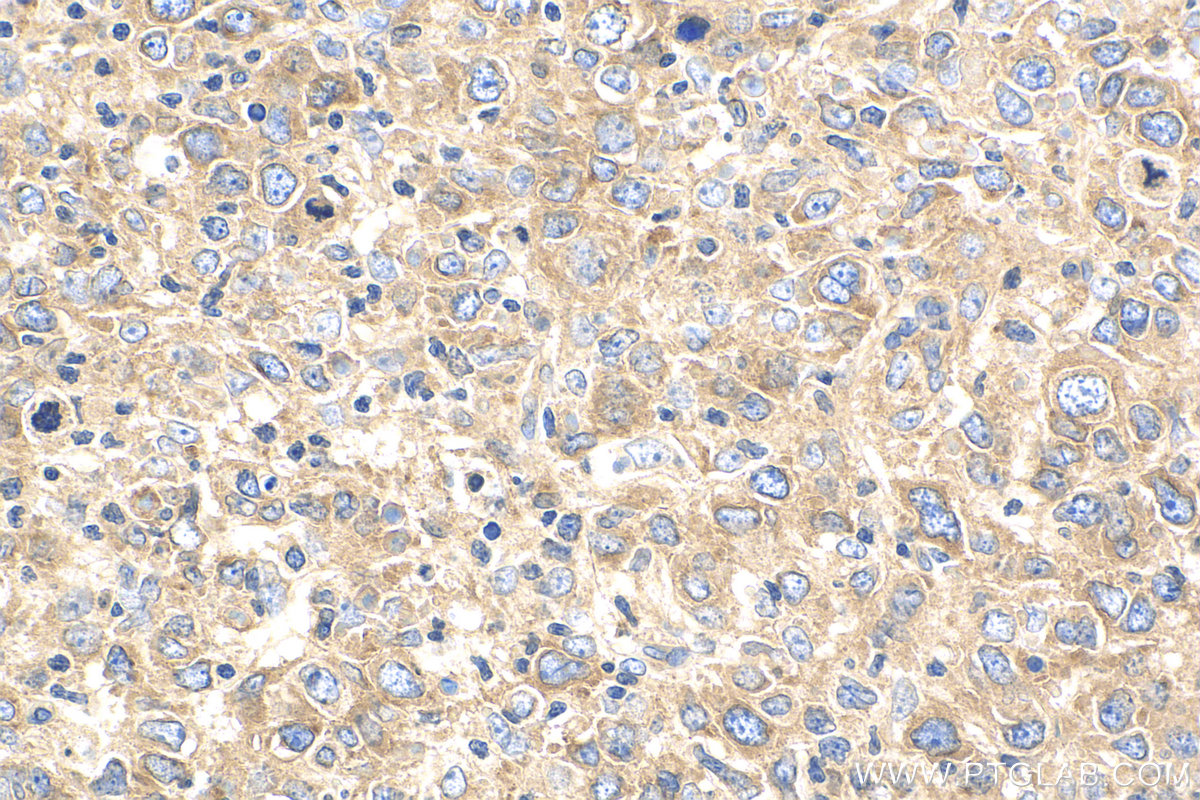

验证数据展示
经过测试的应用
| Positive WB detected in | HCT 116 cells, HeLa cells, mouse heart tissue, rat liver tissue, mouse kidney tissue, mouse liver tissue |
| Positive IHC detected in | human colon cancer tissue, human lymphoma tissue Note: suggested antigen retrieval with TE buffer pH 9.0; (*) Alternatively, antigen retrieval may be performed with citrate buffer pH 6.0 |
推荐稀释比
| 应用 | 推荐稀释比 |
|---|---|
| Western Blot (WB) | WB : 1:500-1:2000 |
| Immunohistochemistry (IHC) | IHC : 1:50-1:500 |
| It is recommended that this reagent should be titrated in each testing system to obtain optimal results. | |
| Sample-dependent, Check data in validation data gallery. | |
产品信息
29862-1-AP targets ENT1 in WB, IHC, IF, ELISA applications and shows reactivity with human, mouse, rat samples.
| 经测试应用 | WB, IHC, ELISA Application Description |
| 文献引用应用 | WB, IHC, IF |
| 经测试反应性 | human, mouse, rat |
| 文献引用反应性 | human, mouse |
| 免疫原 |
CatNo: Ag32003 Product name: Recombinant human ENT1 protein Source: e coli.-derived, PGEX-4T Tag: GST Domain: 30-82 aa of NM_001372327.1 Sequence: NFFMTATQYFTNRLDMSQNVSLVTAELSKDAQASAAPAAPLPERNSLSAIFNN 种属同源性预测 |
| 宿主/亚型 | Rabbit / IgG |
| 抗体类别 | Polyclonal |
| 产品类型 | Antibody |
| 全称 | solute carrier family 29 (nucleoside transporters), member 1 |
| 别名 | ENT-1, Equilibrative NBMPR-sensitive nucleoside transporter, Equilibrative nitrobenzylmercaptopurine riboside-sensitive nucleoside transporter, es nucleoside transporter, Nucleoside transporter, es-type |
| 计算分子量 | 50KD |
| 观测分子量 | 70 kDa |
| GenBank蛋白编号 | NM_001372327.1 |
| 基因名称 | ENT1 |
| Gene ID (NCBI) | 2030 |
| RRID | AB_2935484 |
| 偶联类型 | Unconjugated |
| 形式 | Liquid |
| 纯化方式 | Antigen affinity purification |
| UNIPROT ID | Q99808 |
| 储存缓冲液 | PBS with 0.02% sodium azide and 50% glycerol, pH 7.3. |
| 储存条件 | Store at -20°C. Stable for one year after shipment. Aliquoting is unnecessary for -20oC storage. |
背景介绍
ENT1 (equilibrative nucleoside transporter 1; also known as SLC29A1) is a ubiquitous protein located at the cell membrane and is a major transporter responsible for the cellular uptake and release of endogenous nucleosides such as adenosine, and nucleoside analogs used in chemotherapy. The predicted molecular weight of ENT1 is 50 kDa, while heavier 54-68 kDa band may be observed due to the glycosylation (PMID: 16448802, 11850433, 16111480). A smaller novel splice variant of the mouse ENT1 has also been identified, which generates a protein of 35-40 kDa (PMID: 18413666).
实验方案
| Product Specific Protocols | |
|---|---|
| IHC protocol for ENT1 antibody 29862-1-AP | Download protocol |
| WB protocol for ENT1 antibody 29862-1-AP | Download protocol |
| Standard Protocols | |
|---|---|
| Click here to view our Standard Protocols |
发表文章
| Species | Application | Title |
|---|---|---|
Cell Mol Gastroenterol Hepatol Extracellular Inosine Induces Anergy in B Cells to Alleviate Autoimmune Hepatitis | ||
Fluids Barriers CNS Cocaine regulates antiretroviral therapy CNS access through pregnane-x receptor-mediated drug transporter and metabolizing enzyme modulation at the blood brain barrier | ||
Hippocampus Anticonvulsant effect of equilibrative nucleoside transporters 1 inhibitor in a mouse model of Dravet syndrome | ||
Proc Natl Acad Sci U S A Pharmacological inhibition of ENT1 enhances the impact of specific dietary fats on energy metabolism gene expression | ||
J Clin Med A New Histology-Based Prognostic Index for Acute Myeloid Leukemia: Preliminary Results for the "AML Urayasu Classification" |